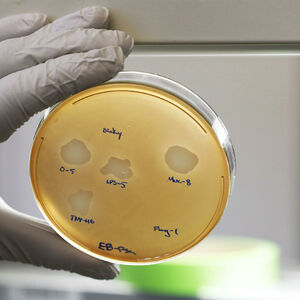

zastrašujuće
ZBOG UMORA I BOLOVA OTIŠAO U BOLNICU, A LEKARI OSTALI U ŠOKU: Imao simptome prehlade, a napalo ga nešto JEZIVO
Pacijent je došao na pregled jer je već tri meseca osećao slabost i simptome kao što su kašalj, promukao glas, bol u grlu i otežano gutanje
Želeo je da brzo ozdravi da bi mogao da se vrati na posao. Standardnim testovima u njegovom telu je otkriveno nešto što stručnjaci širom sveta nikada nisu videli. Dijagnostikovana mu je infekcija koja je prvi put napala čoveka. Do sada je bila odgovorna za uginuće drveća.
Pacijent iz Indije je došao na pregled jer je već tri meseca osećao slabost i simptome kao što su kašalj, promukao glas, bol u grlu i otežano gutanje. 61-godišnji muškarac je detaljno pregledan. Lekari nisu mogli da veruju šta su otkrili.
Prvi takav slučaj u svetu. Na vratu muškarca pronađena je gljivica
Faringitis, umor i anoreksija nisu bili simptomi obične prehlade. U procesu traženja uzroka malaksalosti pacijenta , lekari su uradili CT vrata, a zatim i grudnog koša.
Na grudima 61-godišnjeg muškarca nije bilo značajnijih promena, dok mu je na vratu pronađen apsces. Lekari su iz njega uzeli uzorke i potom ga poslali na analizu u Centar za referentne i istraživačke gljive od medicinskog značaja, koji sarađuje sa SZO.
Lekari nisu verovali šta su pronašli u telu pacijenta
Analize uzoraka su pokazale da se ono što je otkriveno na vratu pacijenta ispostavilo da je gljivica koja se ranije pojavljivala samo na drveću . Ovaj 61-godišnjak je sproveo istraživanje o biljnim gljivama. To znači da je možda bio u kontaktu sa ovom gljivicom. Upravo je ova gljivica pronađena u njegovom telu.
Od miliona gljivica koje se nalaze u životnoj sredini, samo nekoliko stotina je u stanju da zarazi ljude i životinje. Do nedavno, purple chondroderma nije bila jedna od njih. Slučaj dokumentovan od strane Medical Micologi Case Reports u martu 2023. prvi je te vrste u svetu.
Opasna drvna gljivica napala čoveka
Purple fungus je vrsta gljivica koja se nalazi na drveću (obično listopadnom) u različitim klimatskim uslovima. Najčešće se može naći na oštećenim površinama drveća.
Ova gljivica loše utiče na stanje drveća, zbog čega su zaštićena. Drveće napadnuto ljubičastim gljivica može se spasiti sečenjem obolelih grana.
Bonus video:
(Espreso/ Naj Žena)
Uz Espreso aplikaciju nijedna druga vam neće trebati. Instalirajte i proverite zašto!